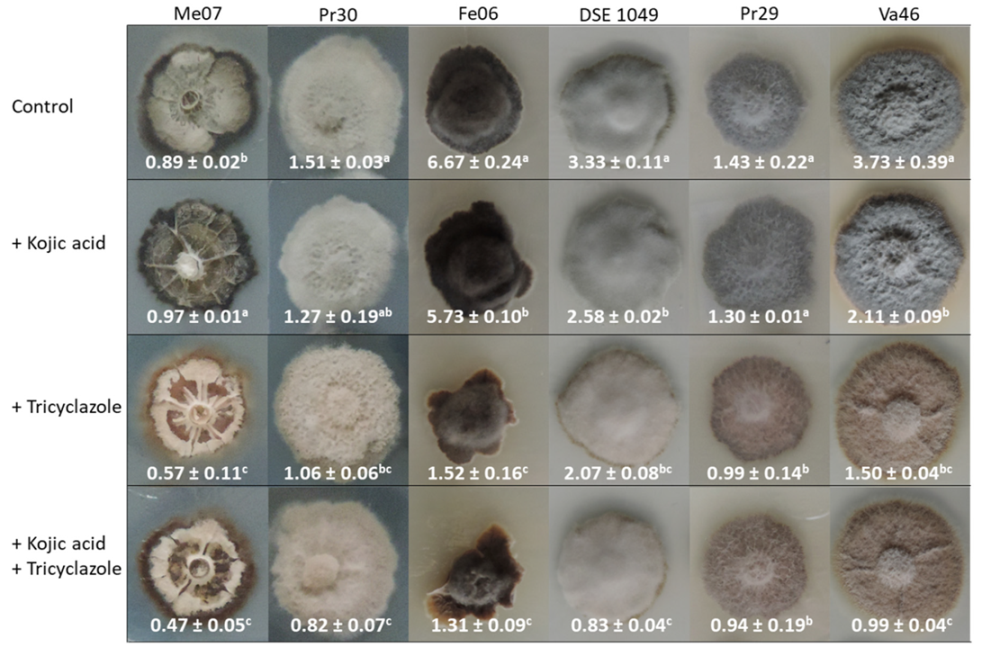
Microorganisms 08 00537 g002 Microorganisms 08 00537 g002

Unravelling the Role of Melanin in Cd and Zn Tolerance and Accumulation of Three Dark Septate Endophytic Species
Abstract
1. Introduction
2. Materials and Methods
2.1. Searching for Homologous Genes
2.2. Strains and Culture Medium
2.3. Strain Sensitivity to Melanin Inhibitors and to TE
2.4. Effect of Melanin Inhibitors and TE on Mycelial Melanin Concentration
2.5. Quantification of TE in Mycelia
2.6. Fourier Transformed Infrared Resonance (FTIR) Analysis
2.7. Statistical Analyses
3. Results
3.1. Enzymes Involved in Melanin Biosynthetic Pathways
3.2. Effect of Biochemical Inhibitors on Melanin Accumulation
3.3. Fourier Transform Infrared Spectroscopy (FTIR) of Melanin from Leptodontidium sp. Me07
3.4. Melanin Accumulation in the Presence of Cd and Zn
3.5. Relationship between Melanin Accumulation and TE Tolerance
3.6. Relationship between Mycelial Melanin Concentration and TE Accumulation
4. Discussion
4.1. Melanin Biosynthetic Pathways in Leptodontidium sp., Cadophora sp., and P. mustea
4.2. Melanin Content and TE Tolerance
4.3. Melanin Content and TE Accumulation
5. Conclusion
Supplementary Materials
Author Contributions
Funding
Acknowledgments
Conflicts of Interest
References
- Jumpponen, A.; Trappe, J.M. Dark septate endophytes: A review with special reference to facultative biotrophic root-colonizing fungi. New Phytol. 1998, 140, 295–310. [Google Scholar] [CrossRef]
- Mandyam, K.; Jumpponen, A. Seeking the elusive function of the root-colonising dark septate endophytic fungi. Stud. Mycol. 2005, 53, 173–189. [Google Scholar] [CrossRef]
- Likar, M.; Regvar, M. Isolates of dark septate endophytes reduce metal uptake and improve physiology of Salix caprea L. Plant Soil 2013, 370, 593–604. [Google Scholar] [CrossRef]
- Knapp, D.G.; Imrefi, I.; Boldpurev, E.; Csíkos, S.; Akhmetova, G.; Berek-Nagy, P.J.; Otgonsuren, B.; Kovács, G.M. Root-colonizing endophytic fungi of the dominant grass Stipa krylovii from a Mongolian steppe grassland. Front. Microbiol. 2019, 10, 1–13. [Google Scholar] [CrossRef] [PubMed]
- T Rayment, J.; Jones, S.; French, K. Seasonal patterns of fungal colonisation in Australian native plants of different ages. Symbiosis 2020, 80, 169–182. [Google Scholar] [CrossRef]
- Ruotsalainen, A.L.; Markkola, A.; Kozlov, M.V. Root fungal colonisation in Deschampsia flexuosa: Effects of pollution and neighbouring trees. Environ. Pollut. 2007, 147, 723–728. [Google Scholar] [CrossRef]
- Zhang, Y.; Li, T.; Zhao, Z.-W. Colonization characteristics and composition of dark septate endophytes (DSE) in a lead and zinc slag heap in southwest China. Soil Sediment Contam. Int. J. 2013, 22, 532–545. [Google Scholar] [CrossRef]
- Ban, Y.; Tang, M.; Chen, H.; Xu, Z.; Zhang, H.; Yang, Y. The response of dark septate endophytes (DSE) to heavy metals in pure culture. PLoS ONE 2012, 7, e47968. [Google Scholar] [CrossRef]
- Berthelot, C.; Leyval, C.; Foulon, J.; Chalot, M.; Blaudez, D. Plant growth promotion, metabolite production and metal tolerance of dark septate endophytes isolated from metal-polluted poplar phytomanagement sites. FEMS Microbiol. Ecol. 2016, 92, fiw144. [Google Scholar] [CrossRef]
- Gorfer, M.; Persak, H.; Berger, H.; Brynda, S.; Bandian, D.; Strauss, J. Identification of heavy metal regulated genes from the root associated ascomycete Cadophora finlandica using a genomic microarray. Mycol. Res. 2009, 113, 1377–1388. [Google Scholar] [CrossRef]
- Zhao, D.; Li, T.; Wang, J.; Zhao, Z. Diverse strategies conferring extreme cadmium (Cd) tolerance in the dark septate endophyte (DSE), Exophiala pisciphila: Evidence from RNA-seq data. Microbiol. Res. 2015, 170, 27–35. [Google Scholar] [CrossRef] [PubMed]
- Cao, G.H.; He, S.; Chen, D.; Li, T.; Zhao, Z.W. EpABC genes in the adaptive responses of Exophiala pisciphila to metal stress: Functional importance and relation to metal tolerance. Appl. Environ. Microbiol. 2019, 85, 1–16. [Google Scholar] [CrossRef] [PubMed]
- Zhu, L.; Li, T.; Wang, C.; Zhang, X.; Xu, L.; Xu, R.; Zhao, Z. The effects of dark septate endophyte (DSE) inoculation on tomato seedlings under Zn and Cd stress. Environ. Sci. Pollut. Res. 2018, 25, 35232–35241. [Google Scholar] [CrossRef] [PubMed]
- Zhan, F.; Li, B.; Jiang, M.; Qin, L.; Wang, J.; He, Y.; Li, Y. Effects of a root-colonized dark septate endophyte on the glutathione metabolism in maize plants under cadmium stress. J. Plant Interact. 2017, 12, 421–428. [Google Scholar] [CrossRef]
- He, Y.; Yang, Z.; Li, M.; Jiang, M.; Zhan, F.; Zu, Y.; Li, T.; Zhao, Z. Effects of a dark septate endophyte (DSE) on growth, cadmium content, and physiology in maize under cadmium stress. Environ. Sci. Pollut. Res. 2017, 24, 18494–18504. [Google Scholar] [CrossRef]
- Berthelot, C.; Blaudez, D.; Leyval, C. Differential growth promotion of poplar and birch inoculated with three dark septate endophytes in two trace element-contaminated soils. Int. J. Phytoremediat. 2017, 19, 1118–1125. [Google Scholar] [CrossRef]
- Berthelot, C.; Blaudez, D.; Beguiristain, T.; Chalot, M.; Leyval, C. Co-inoculation of Lolium perenne with Funneliformis mosseae and the dark septate endophyte Cadophora sp. in a trace element-polluted soil. Mycorrhiza 2018, 28, 301–314. [Google Scholar] [CrossRef]
- Ban, Y.; Xu, Z.; Yang, Y.; Zhang, H.; Chen, H.; Tang, M. Effect of dark septate endophytic fungus Gaeumannomyces cylindrosporus on plant growth, photosynthesis and Pb tolerance of maize (Zea mays L.). Pedosphere 2017, 27, 283–292. [Google Scholar] [CrossRef]
- Zhan, F.; He, Y.; Zu, Y.; Li, T.; Zhao, Z. Characterization of melanin isolated from a dark septate endophyte (DSE), Exophiala pisciphila. World J. Microbiol. Biotechnol. 2011, 27, 2483–2489. [Google Scholar] [CrossRef]
- Zhan, F.; He, Y.; Yang, Y.; Li, Y.; Li, T. Effects of tricyclazole on cadmium tolerance and accumulation characteristics of a dark septate endophyte (DSE), Exophiala pisciphila. Bull. Environ. Contam. Toxicol. 2016, 96, 235–241. [Google Scholar] [CrossRef]
- Butler, M.; Day, A. Fungal melanins: A review. Can. J. Microbiol. 1998, 44, 1115–1136. [Google Scholar] [CrossRef]
- Gessler, N.N.; Egorova, A.S.; Belozerskaya, T.A. Melanin pigments of fungi under extreme environmental conditions (Review). Appl. Biochem. Microbiol. 2014, 50, 105–113. [Google Scholar] [CrossRef]
- Fogarty, R.V.; Tobin, J.M. Fungal melanins and their interaction with metals. Enzyme Microb. Technol. 1996, 19, 311–317. [Google Scholar] [CrossRef]
- Wheeler, B.M.H. Comparisons of fungal melanin biosynthesis in ascomycetous, imperfect and basidiomycetous fungi. Trans. Br. Mycol. Soc. 1983, 81, 29–36. [Google Scholar] [CrossRef]
- Gonçalves, R.C.R.; Lisboa, H.C.F.; Pompeiro-Sponchiado, S.R. Characterization of melanin pigment produced by Aspergillus nidulans. World J. Microbiol. Biotechnol. 2012, 28, 1467–1474. [Google Scholar] [CrossRef] [PubMed]
- Frederick, B.A.; Caesar-Tonthat, T.-C.; Wheeler, M.H.; Sheehan, K.B.; Edens, W.A.; Henson, J.M. Isolation and characterisation of Gaeumannomyces graminis var. graminis melanin mutants. Mycol. Res. 1999, 103, 99–110. [Google Scholar] [CrossRef]
- Butler, M.J.; Gardiner, R.B.; Day, A.W. Degradation of melanin or inhibition of its synthesis: Are these a significant approach as a biological control of phytopathogenic fungi? Biol. Control 2005, 32, 326–336. [Google Scholar] [CrossRef]
- Knapp, D.G.; Németh, J.B.; Barry, K.; Hainaut, M.; Henrissat, B.; Johnson, J.; Kuo, A.; Lim, J.H.P.; Lipzen, A.; Nolan, M.; et al. Comparative genomics provides insights into the lifestyle and reveals functional heterogeneity of dark septate endophytic fungi. Sci. Rep. 2018, 8, 1–13. [Google Scholar] [CrossRef]
- Gadd, G.M.; de Rome, L. Biosorption of copper by fungal melanin. Appl. Microbiol. Biotechnol. 1988, 29, 610–617. [Google Scholar] [CrossRef]
- Siegel, S.M.; Galun, M.; Siegel, B.Z. Filamentous fungi as metal biosorbents: A review. Water Air Soil Pollut. 1990, 53, 335–344. [Google Scholar] [CrossRef]
- Grigoriev, I.V.; Nikitin, R.; Haridas, S.; Kuo, A.; Ohm, R.; Otillar, R.; Riley, R.; Salamov, A.; Zhao, X.; Korzeniewski, F.; et al. MycoCosm portal: Gearing up for 1000 fungal genomes. Nucleic Acids Res. 2014, 42, 699–704. [Google Scholar] [CrossRef] [PubMed]
- Tsai, H.; Wheeler, M.H.; Chang, Y.C. A developmentally regulated gene cluster involved in conidial pigment biosynthesis in Aspergillus fumigatus. J. Bacteriol. 1999, 181, 6469–6477. [Google Scholar] [CrossRef] [PubMed]
- Eisenman, H.C.; Casadevall, A. Synthesis and assembly of fungal melanin. Appl. Microbiol. Biotechnol. 2012, 93, 931–940. [Google Scholar] [CrossRef] [PubMed]
- Nierman, W.C.; Pain, A.; Anderson, M.J.; Wortman, J.R.; Kim, H.S.; Arroyo, J.; Berriman, M.; Abe, K.; Archer, D.B.; Bermejo, C.; et al. Genomic sequence of the pathogenic and allergenic filamentous fungus Aspergillus fumigatus. Nature 2005, 438, 1151–1156. [Google Scholar] [CrossRef] [PubMed]
- Arnaud, M.B.; Cerqueira, G.C.; Inglis, D.O.; Skrzypek, M.S.; Binkley, J.; Chibucos, M.C.; Crabtree, J.; Howarth, C.; Orvis, J.; Shah, P.; et al. The Aspergillus Genome Database (AspGD): Recent developments in comprehensive multispecies curation, comparative genomics and community resources. Nucleic Acids Res. 2012, 40, D653–D659. [Google Scholar] [CrossRef] [PubMed]
- Li, X.Q.; Guo, B.L.; Cai, W.Y.; Zhang, J.M.; Huang, H.Q.; Zhan, P.; Xi, L.Y.; Vicente, V.A.; Stielow, B.; Sun, J.F.; et al. The role of melanin pathways in extremotolerance and virulence of Fonsecaea revealed by de novo assembly transcriptomics using illumina paired-end sequencing. Stud. Mycol. 2016, 83, 1–18. [Google Scholar] [CrossRef]
- Teixeira, M.M.; Moreno, L.F.; Stielow, B.J.; Muszewska, A.; Hainaut, M.; Gonzaga, L.; Abouelleil, A.; Patané, J.S.L.; Priest, M.; Souza, R.; et al. Exploring the genomic diversity of black yeasts and relatives (Chaetothyriales, Ascomycota). Stud. Mycol. 2017, 86, 1–28. [Google Scholar] [CrossRef]
- Chen, Z.; Martinez, D.A.; Gujja, S.; Sykes, S.M.; Zeng, Q.; Szaniszlo, P.J.; Wang, Z.; Cuomo, C.A. Comparative genomic and transcriptomic analysis of Wangiella dermatitidis, a major cause of phaeohyphomycosis and a model black yeast human pathogen. G3 Genes Genomes Genet. 2014, 4, 561–578. [Google Scholar]
- Vági, P.; Knapp, D.G.; Kósa, A.; Seress, D.; Horváth, Á.N.; Kovács, G.M. Simultaneous specific in planta visualization of root-colonizing fungi using fluorescence in situ hybridization (FISH). Mycorrhiza 2014, 24, 259–266. [Google Scholar] [CrossRef]
- Berthelot, C.; Perrin, Y.; Leyval, C.; Blaudez, D. Melanization and ageing are not drawbacks for successful agro-transformation of dark septate endophytes. Fungal Biol. 2017, 121, 652–663. [Google Scholar] [CrossRef]
- Pachlewski, R.; Pachlewska, J. Studies on Symbiotic Properties of Mycorrhizal Fungi of Pine (Pinus sylvestris L.) with the Aid of the Method of Mycorrhizal Synthesis in Pure Cultures on Agar; Forest Research Institute Press: Warsaw, Poland, 1974; Volume 228. [Google Scholar]
- Almeida-Paes, R.; Frases, S.; de Sousa Araujo, G.; Evangelista de Oliveira, M.M.; Gerfen, G.J.; Nosanchuk, J.D.; Zancopo-Oliveira, R.M. Biosynthesis and functions of a melanoid pigment produced by species of the sporothrix complex in the presence of L-Tyrosine. Appl. Environ. Microbiol. 2012, 78, 8623–8630. [Google Scholar] [CrossRef] [PubMed]
- Zou, Y.; Xie, C.; Fan, G.; Gu, Z.; Han, Y. Optimization of ultrasound-assisted extraction of melanin from Auricularia auricula fruit bodies. Innov. Food Sci. Emerg. Technol. 2010, 11, 611–615. [Google Scholar] [CrossRef]
- Baldrian, P. Fungal laccases occurrence and properties. FEMS Microbiol. Rev. 2006, 30, 215–242. [Google Scholar] [CrossRef]
- Fujieda, N.; Murata, M.; Yabuta, S.; Ikeda, T.; Shimokawa, C.; Nakamura, Y.; Hata, Y.; Shinobu, I. Multifunctions of MelB, a fungal tyrosinase from Aspergillus oryzae. ChemBioChem 2012, 13, 193–201. [Google Scholar] [CrossRef]
- Kunova, A.; Pizzatti, C.; Cortesi, P. Impact of tricyclazole and azoxystrobin on growth, sporulation and secondary infection of the rice blast fungus, Magnaporthe oryzae. Pest Manag. Sci. 2013, 69, 278–284. [Google Scholar] [CrossRef] [PubMed]
- Youngchim, S. Production of melanin by Aspergillus fumigatus. J. Med. Microbiol. 2004, 53, 175–181. [Google Scholar] [CrossRef] [PubMed]
- Weijn, A.; Bastiaan-Net, S.; Wichers, H.J.; Mes, J.J. Melanin biosynthesis pathway in Agaricus bisporus mushrooms. Fungal Genet. Biol. 2013, 55, 42–53. [Google Scholar] [CrossRef]
- Henson, J.M.; Butler, M.J.; Day, A.W. The dark side of the mycelium: Melanins of phytopathogenic fungi. Annu. Rev. Phytopathol. 1999, 97, 447–471. [Google Scholar] [CrossRef]
- Pal, A.K.; Gajjar, D.U.; Vasavada, A.R. DOPA and DHN pathway orchestrate melanin synthesis in Aspergillus species. Med. Mycol. 2013, 52, 1–9. [Google Scholar] [CrossRef]
- Tripathi, P.; Srivastava, S. Development and characterization of nickel accumulating mutants of Aspergillus nidulans. Indian J. Microbiol. 2007, 47, 241–250. [Google Scholar] [CrossRef][Green Version]
- Tripathi, P.; Srivastava, S. Mechanism to combat cobalt toxicity in cobalt resistant mutants of Aspergillus nidulans. Indian J. Microbiol. 2007, 47, 336–344. [Google Scholar] [CrossRef] [PubMed]
- Zhan, F.; He, Y.; Li, Y.; Li, T.; Yang, Y.-Y.; Toor, G.S.; Zhao, Z. Subcellular distribution and chemical forms of cadmium in a dark septate endophyte (DSE), Exophiala pisciphila. Environ. Sci. Pollut. Res. 2015, 22, 17897–17905. [Google Scholar] [CrossRef] [PubMed]
- Daghino, S.; Martino, E.; Perotto, S. Model systems to unravel the molecular mechanisms of heavy metal tolerance in the ericoid mycorrhizal symbiosis. Mycorrhiza 2016, 26, 263–274. [Google Scholar] [CrossRef] [PubMed]
- Gube, M. Fungal Molecular Response to Heavy Metal Stress. In The Mycota III. Biochemistry and Molecular Biology; Hoffmeister, D., Ed.; Springer: Cham, Switzerland, 2016; pp. 47–68. ISBN 978-3-319-27790-5. [Google Scholar]
- Blaudez, D.; Chalot, M. Characterization of the ER-located zinc transporter ZnT1 and identification of a vesicular zinc storage compartment in Hebeloma cylindrosporum. Fungal Genet. Biol. 2011, 48, 496–503. [Google Scholar] [CrossRef] [PubMed]
- Khouja, H.R.; Abbà, S.; Lacercat-Didier, L.; Daghino, S.; Doillon, D.; Richaud, P.; Martino, E.; Vallino, M.; Perotto, S.; Chalot, M.; et al. OmZnT1 and OmFET, two metal transporters from the metal-tolerant strain Zn of the ericoid mycorrhizal fungus Oidiodendron maius, confer zinc tolerance in yeast. Fungal Genet. Biol. 2013, 52, 53–64. [Google Scholar] [CrossRef]
- Hong, L.; Simon, J.D. Current understanding of the binding sites, capacity, affinity and biological significance of metals in melanin. J. Phys. Chem. B 2007, 111, 7938–7947. [Google Scholar] [CrossRef]
- Gadd, G.M. Mechanisms implicated in the ecological success of polymorphic fungi in metal-polluted habitats. Environ. Technol. 1981, 2, 531–536. [Google Scholar] [CrossRef]
- Caesar-Tonthat, T.C.; Van Ommen, F.; Geesey, G.G.; Henson, J.M. Melanin production by a filamentous soil fungus in response to copper and localization of copper sulfide by sulfide-silver staining. Appl. Environ. Microbiol. 1995, 61, 1968–1975. [Google Scholar] [CrossRef]
- Bellion, M.; Courbot, M.; Jacob, C.; Blaudez, D.; Chalot, M. Extracellular and cellular mechanisms sustaining metal tolerance in ectomycorrhizal fungi. FEMS Microbiol. Lett. 2006, 254, 173–181. [Google Scholar] [CrossRef]
- Lanfranco, L.; Balsamo, R.; Martino, E.; Perotto, S.; Bonfante, P. Zinc ions alter morphology and chitin deposition in an ericoid fungus. Eur. J. Histochem. 2002, 46, 341–350. [Google Scholar] [CrossRef]

© 2020 by the authors. Licensee MDPI, Basel, Switzerland. This article is an open access article distributed under the terms and conditions of the Creative Commons Attribution (CC BY) license (http://creativecommons.org/licenses/by/4.0/).
Share and Cite
Berthelot, C.; Zegeye, A.; Gaber, D.A.; Chalot, M.; Franken, P.; Kovács, G.M.; Leyval, C.; Blaudez, D. Unravelling the Role of Melanin in Cd and Zn Tolerance and Accumulation of Three Dark Septate Endophytic Species. Microorganisms 2020, 8, 537. https://doi.org/10.3390/microorganisms8040537
Berthelot C, Zegeye A, Gaber DA, Chalot M, Franken P, Kovács GM, Leyval C, Blaudez D. Unravelling the Role of Melanin in Cd and Zn Tolerance and Accumulation of Three Dark Septate Endophytic Species. Microorganisms. 2020; 8(4):537. https://doi.org/10.3390/microorganisms8040537
Chicago/Turabian StyleBerthelot, Charlotte, Asfaw Zegeye, Dalia A. Gaber, Michel Chalot, Philipp Franken, Gábor M. Kovács, Corinne Leyval, and Damien Blaudez. 2020. "Unravelling the Role of Melanin in Cd and Zn Tolerance and Accumulation of Three Dark Septate Endophytic Species" Microorganisms 8, no. 4: 537. https://doi.org/10.3390/microorganisms8040537
APA StyleBerthelot, C., Zegeye, A., Gaber, D. A., Chalot, M., Franken, P., Kovács, G. M., Leyval, C., & Blaudez, D. (2020). Unravelling the Role of Melanin in Cd and Zn Tolerance and Accumulation of Three Dark Septate Endophytic Species. Microorganisms, 8(4), 537. https://doi.org/10.3390/microorganisms8040537
